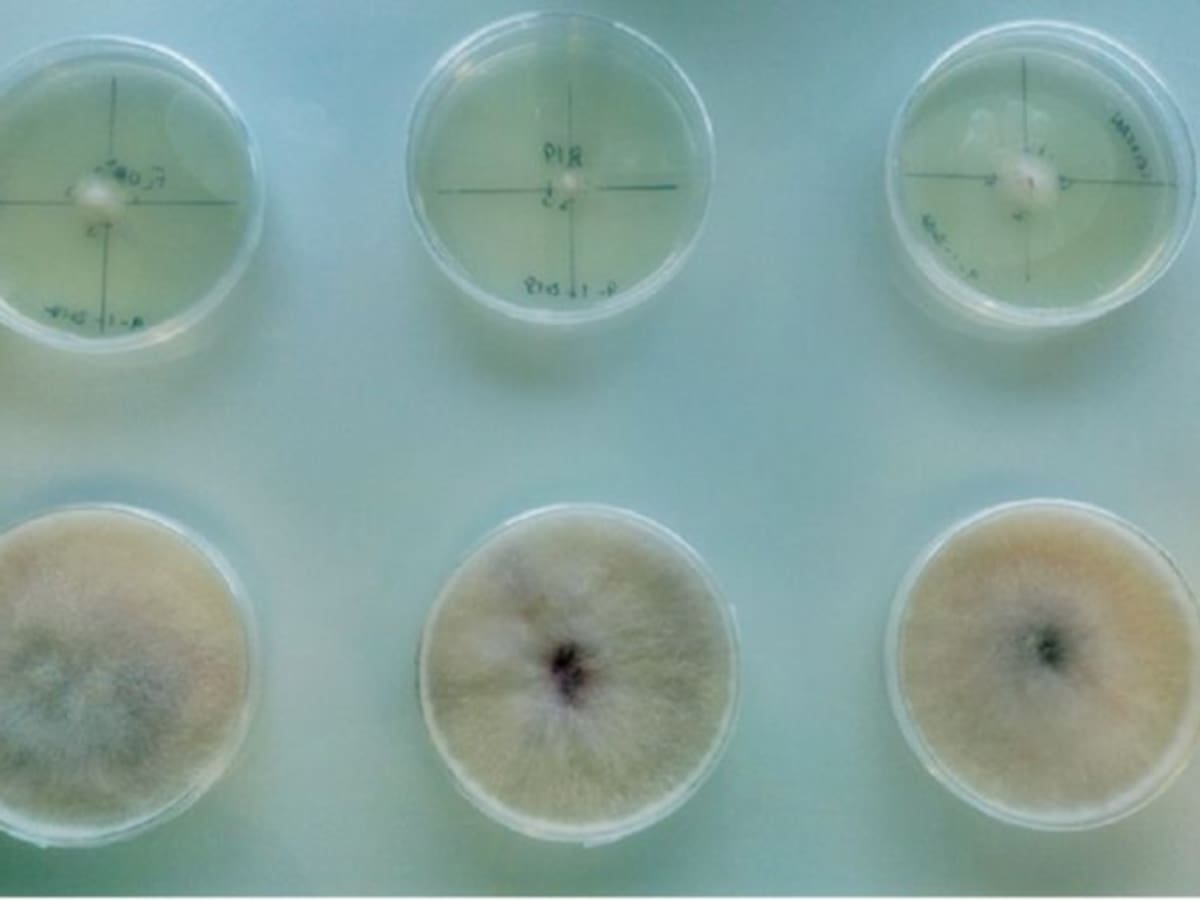

El número de casos de 'Xyella Fastidiosa' se ha multiplicado por siete en un año
La conselleria de Medio Ambiente y Agricultura registra 627 positivos en Balears
14/03/2018 - 14:21
Peter Tchernokojev
PALMA
Selecciona tu emisora

La conselleria de Medio Ambiente y Agricultura registra 627 positivos en Balears
14/03/2018 - 14:21
Peter Tchernokojev
PALMA

12/03/2018 - 12:15
Redacción
Ibiza

20/02/2018 - 12:06

19/02/2018 - 12:30

19/02/2018 - 11:39
Juan Magraner
Valencia
16/02/2018 - 19:10
Redacción
Palencia

18/01/2018 - 11:11
Míriam Pagán | Redacción
Dénia

01/12/2017 - 19:24
Carmen Vela
París

26/11/2016 - 08:10
Jèssica Crespo
Valencia

16/11/2016 - 14:20
Nuria Rodríguez
Carracedelo

13/11/2016 - 14:52
Peter Tchernokojev
Palma de Mallorca

13/09/2016 - 11:24
Redacción
Palencia

10/05/2016 - 11:30
Juan Magraner
Valencia

05/11/2015 - 18:07
Juan Francisco Rojo
Palencia
Ahora en directo
Cadena SER
00:00 - 23:59
00:00 - 23:59
Otros directosCadena SER
00:00 - 23:59
Podcast
Síguenos en
Otros episodios
Cualquier tiempo pasado fue anterior
Tu audio se ha acabado.
Te redirigiremos al directo.
5 "